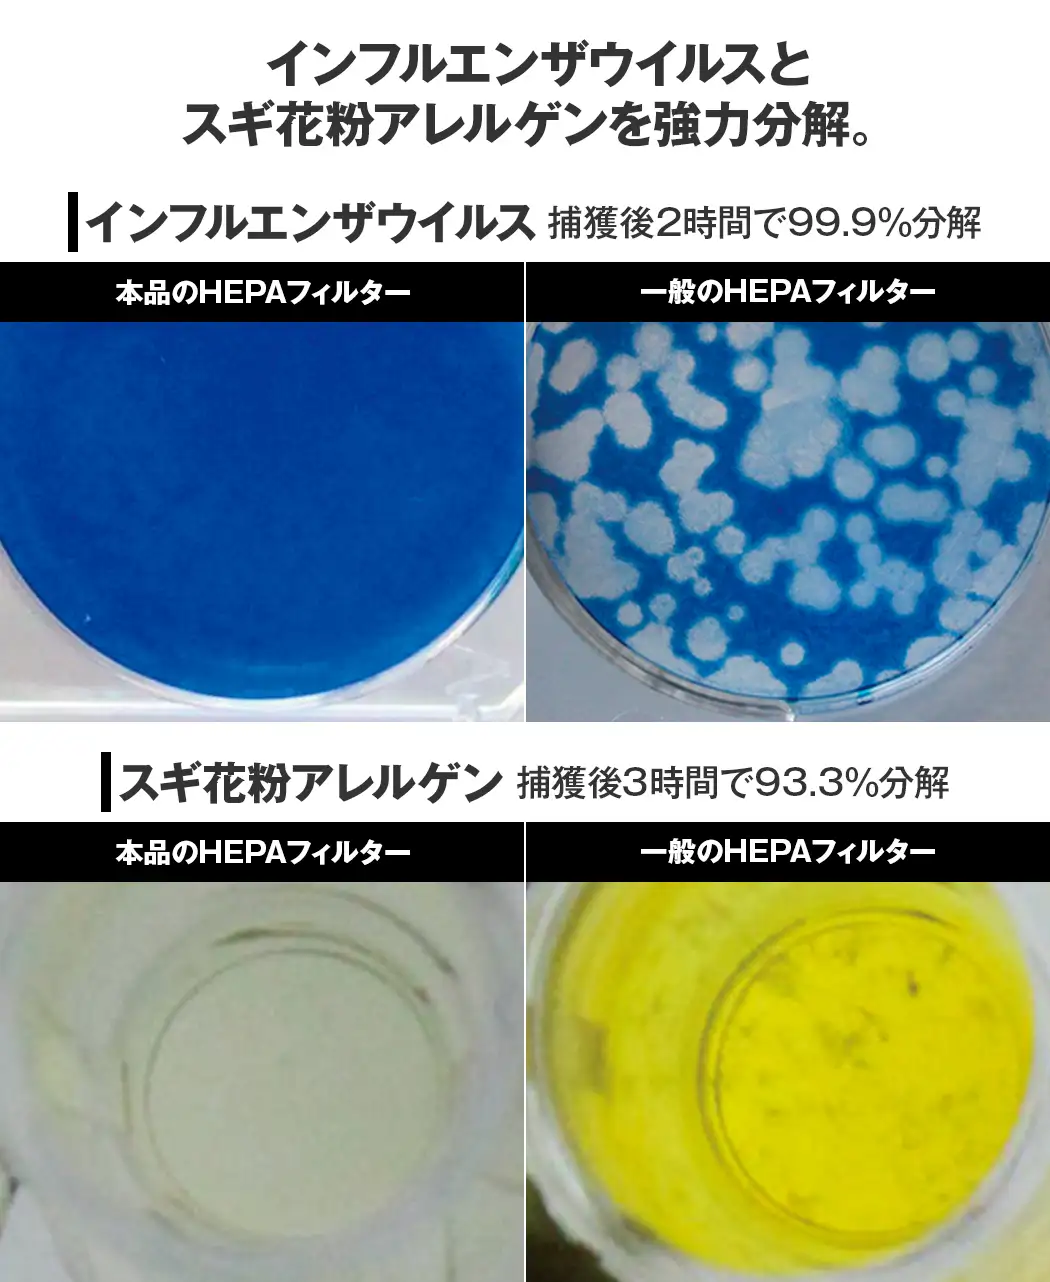
通販生活®空気清浄機「アースプラス」｜【公式】カタログハウスの通販

アースプラス 空気清浄機 HEPAフィルター搭載 再生プラスチックを61%使用した空気清浄機アースプラス™ 業界初のエコ
(3075件)
Pontaパス特典
サンキュー配送
99360円(税込)
994ポイント(1%)
Pontaパス会員ならさらに+1%ポイント還元!
送料
(
)
3062
配送情報
お届け予定日:2026.04.23 4:16までにお届け
※一部地域・離島につきましては、表示のお届け予定日期間内にお届けできない場合があります。
ロットナンバー
5152583009
お買い物の前にチェック!

Pontaパス会員なら
ポイント+1%
ポイント+1%
商品説明





信州セラミックス 業務用 空気清浄機 アースプラス・エアー SA-1016J新品未使用スリムデザインのホワイト空気清浄機、HEPAフィルター搭載で高性能。- タイプ: 空気清浄機- フィルタータイプ: HEPAフィルター- フィルターセット: SANHF-1016 空気清浄フィルターセット- カラー: ホワイト- デザイン: スリムタイプ病院等で使われている高性能ご覧いただきありがとうございます。
| カテゴリー: | 生活家電・空調>>>空気清浄機・イオン発生器>>>空気清浄機 |
|---|---|
| 商品の状態: | 新品、未使用","新品で購入し、一度も使用していない |
| ブランド: | 信州セラミックス |
| 配送料の負担: | 送料込み(出品者負担) |
| 配送の方法: | 未定 |
| 発送元の地域: | 大阪府 |
| 発送までの日数: | 4~7日で発送 |
レビュー
商品の評価:




 4.4点(3075件)
4.4点(3075件)
- 15daisuki
- やっぱり芸人都市伝説は面白い、シリアスとギャグの割合が絶妙ですね。 ヤンキーと貧乏もかなり楽しめた。 このBOXの組み合わせは○でしょう。
- みこ1024
- "いつもTVで観るグラス片手の""お漫才""は1本だけ。 残りの演目はあまり面白くなかった。 控え目な印象のあるヒグチ君が、ドンドン前に出る様はちょっと新鮮で良かった。"
- ぐら虎
- 小泉政権時代の内容がメインなので時代的に古いですが、 友人から借りて初めて見たときに面白さにハマってしまい、 こちらでお買い得価格のこの商品を見つけて購入しました。 何度見ても面白いです。
- cocoyan3
- 娘が待ちに待ったDVDです もう届いて即効で観てました ゲラゲラ笑い声が平和ですぅ
- kajyoo_t
- バカリズムの1人コントが好きなので、フリップ芸(?)で構成された「バカリズム案」は、正直期待外れでした。 でも、バカリズムの高校時代の写真が見られたのは良かったかも(笑)
- さくらんぼ0387
- 東京03は、最高。仕事の合間に見れるのがうれしい
- 毒蛇男
- やっぱり、東京03は最高に面白い!仕事の合間に見れるのがうれしい。
- パパッチOK
- すっっっっごく面白いDVDです! 迷っている方は是非どーそ☆ 03ファンは絶対もっておくべき!!
- はとちょっちゃん
- ドリフターズ特集をテレビの番組でやっているのを見てみんなで大笑い。まさに老若男女、子供からご年配の方まで世代・性別を越えて楽しめると思います。DVD是非欲しいと思い探したところ見つけました。しかも5000円以上は送料無料!すごく嬉しい価格で手に入れることが出来ました。 丁寧な梱包と迅速確実な商品連絡で安心してお買い物できました。みんなを笑顔にさせる一品です。
- いまよし1125
- 福田ひとり酒おもしろかったです。楽しめました。
すべて見る
お店の情報
7,367
連絡・応対
4.3
配送スピード
4.3
梱包
4.3